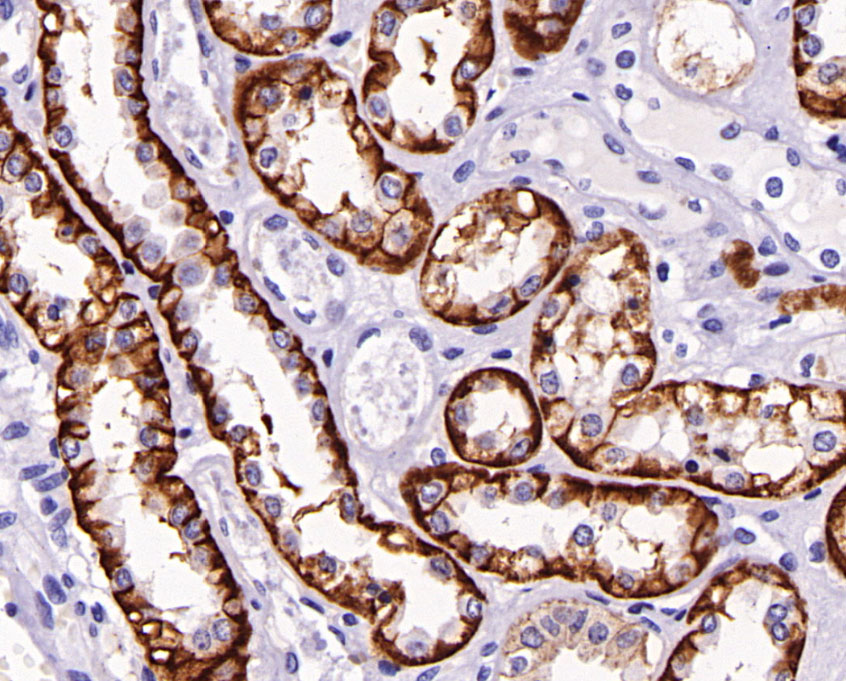
Ksp-Cadherin

产品类型
科研抗体(14098)
病理学产品(574)
免疫学配套产品(2)
生物资源库(194)
产品应用清除
克隆性清除
修饰型清除
宿主种属清除
反应种属清除
种属来源清除
标记方式清除

Copyright © 2021西安鼎国商贸有限责任公司 版权所有 陕ICP备2021003733号

 加入购物车
加入购物车